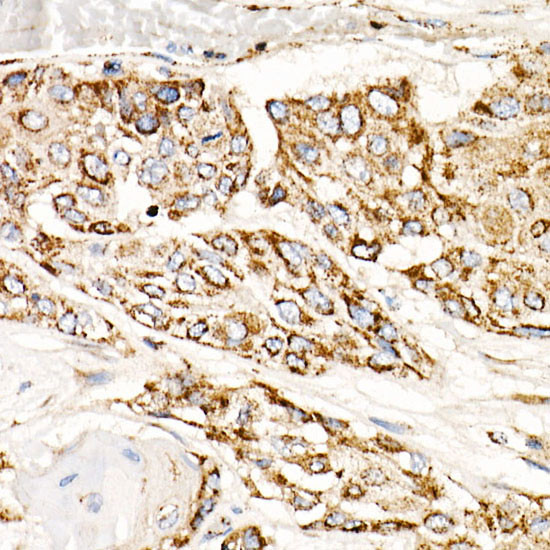
TFAM Antibody in Immunohistochemistry (Paraffin) (IHC (P))

Search
Invitrogen
TFAM Recombinant Rabbit Monoclonal Antibody (4H2M9)
{{$productOrderCtrl.translations['antibody.pdp.commerceCard.promotion.promotions']}}
{{$productOrderCtrl.translations['antibody.pdp.commerceCard.promotion.viewpromo']}}
{{$productOrderCtrl.translations['antibody.pdp.commerceCard.promotion.promocode']}}: {{promo.promoCode}} {{promo.promoTitle}} {{promo.promoDescription}}. {{$productOrderCtrl.translations['antibody.pdp.commerceCard.promotion.learnmore']}}
图: 1 / 4
TFAM Antibody (MA5-35365) in IHC (P)




Please note: We are reviewing Western blot images included in the antibody testing data in our catalog, including those provided by third parties. Unless expressly labeled or annotated as “raw-unedited”, Western blot images included in the antibody testing data in our catalog may have been edited, optimized or otherwise adjusted for presentation.
产品信息
MA5-35365
种属反应
已发表种属
宿主/亚型
Expression System
分类
类型
克隆号
抗原
偶联物
形式
浓度
规格
纯化类型
保存液
内含物
保存条件
运输条件
RRID
产品详细信息
Immunogen sequence: QDAYRAEWQV YKEEISRFKE QLTPSQIMSL EKEIMDKHLK RKAMTKKKEL TLLGKPKRPR SAYNVYVAER FQEAKGDSPQ EKLKTVKENW KNLSDSEKEL Y
靶标信息
Mitochondrial transcription factor A (TFAM) is a crucial protein encoded by nuclear genes, but it is transported from the cytoplasm to mitochondria where it plays a key role in the maintenance and expression of mitochondrial DNA (mtDNA). It regulates the replication and transcription of mtDNA, ensuring the proper functioning of mitochondrial processes. Structurally, TFAM contains a molecular region known as the LC3 interacting region (LIR) motif, which allows it to bind to autophagy proteins such as LC3. This interaction is essential for the autolysosomal pathway, helping to eliminate leaked mtDNA and limit inflammation. TFAM levels vary across tissues, with notable effects on mitochondrial function; high levels can repress mtDNA expression in certain tissues, such as skeletal muscle, and contribute to deficiencies in oxidative phosphorylation (OXPHOS). Conversely, in other tissues like the heart, increased mtDNA copy number maintains a balanced TFAM-to-mtDNA ratio, preserving OXPHOS capacity. TFAM is integral to the packaging, stability, and replication of the mitochondrial genome, and disruptions in TFAM can have severe effects, including implications in neurodegeneration and other diseases related to mtDNA stress.
仅用于科研。不用于诊断过程。未经明确授权不得转售。
生物信息学
蛋白别名: Mitochondrial transcription factor 1; MtTF1; mtTFA; TCF-6; Testis-specific high mobility group protein; testis-specific HMG-box protein m-tsHMG; Transcription factor 6; Transcription factor 6-like 2; Transcription factor A, mitochondrial; TS-HMG
基因别名: AI661103; Hmgts; Mttfa; TCF6; TCF6L2; TFAM; tsHMG
UniProt ID: (Rat) Q91ZW1, (Mouse) P40630
Entrez Gene ID: (Rat) 83474, (Mouse) 21780